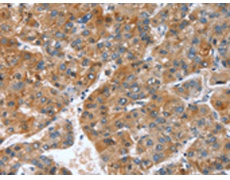
一抗

中文名稱: 兔抗GINS1多克隆抗體
英文名稱: Anti-GINS1 rabbit polyclonal antibody
抗 原: GINS1
反應種屬: Human, Mouse
|
Background: |
DNA replication complex GINS protein PSF1 is a protein that in humans is encoded by the GINS1 gene. The GINS complex plays an essential role in the initiation of DNA replication, and progression of DNA replication forks. GINS complex seems to bind preferentially to single-stranded DNA. GINS1 is essential for function. Component of the GINS complex which is a heterotetramer of GINS1, GINS2, GINS3 and GINS4. Forms a stable subcomplex with GINS4. GINS complex interacts with DNA primase in vitro. |
|
Applications: |
ELISA, IHC |
|
Name of antibody: |
GINS1 |
|
Immunogen: |
Synthetic peptide of human GINS1 |
|
Full name: |
GINS complex subunit 1 (Psf1 homolog) |
|
Synonyms: |
PSF1; RP4-691N24.2 |
|
SwissProt: |
Q14691 |
|
ELISA Recommended dilution: |
1000-2000 |
|
IHC positive control: |
Human liver cancer and Human thyroid cancer |
|
IHC Recommend dilution: |
25-100 |

 購物車
購物車 幫助
幫助
 021-54845833/15800441009
021-54845833/15800441009